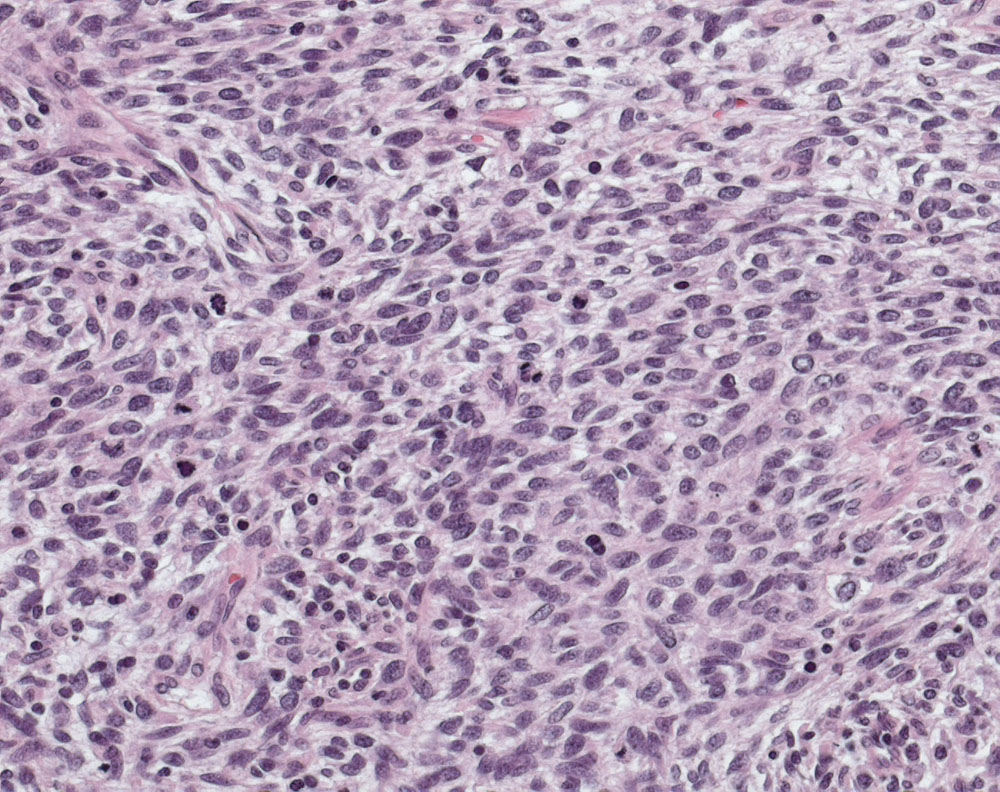
Pathorama

Sarcomitrium es un género de musgos hepáticas perteneciente a la familia Aneuraceae. Comprende 2 especies descritas:[1]
Taxonomía
El género fue descrito por Barthélemy Charles Joseph Dumortier y publicado en Deutschlands Flora, Abtheilung II, Cryptogamie 26–27: 119. 1835.[2]
Especies aceptadas
A continuación se brinda un listado de las especies del género Sarcomitrium aceptadas hasta diciembre de 2014, ordenadas alfabéticamente. Para cada una se indica el nombre binomial seguido del autor, abreviado según las convenciones y usos.
- Sarcomitrium crassum (Nees) Mitt.
- Sarcomitrium plumosum Mitt.
Referencias